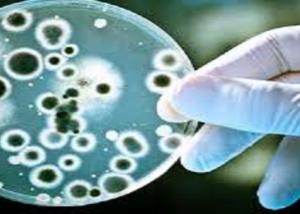

-
IT DATA تعلن عن منحة MCITP في مراكزها المعتمدة للطلبة والخريجين بتكلفة منخفضة
-
الفيسبوكبون يشنون هجوم الكترونيا على موقع توفيق عكاشة
-
اشترك في مسابقة 2012 جنيه دهب من " موبينيل " واكسب جنيهات ذهبيةيومياً واسبوعياً وشهرياً
-
كيونت تطرح "بيور هوم" لمواجهة تلوث مياه الشرب فى مصر بعد الثورة
-
فى مذكرة ل شرف : سكان مدينة العبور يطالبون بنقلهم اداريا لمحافظة القاهرة
-
ب 5000 دولار : "امراة الية " لاقامة علاقات عاطفية مع الرجل
-
من ابناء القطاع : 3 مرشحين لتولى منصب وزير الاتصالات
-
اقبال كبير على التعليم الالكترونى فى مصر لقدرته على ايصال المعلومة اسرع وأقل تكلفة
-
"فودافون" تنفى القبض على 3 من موظفيها لبيعهم كروت بأسعار مخالفة للتسعيرة.. وتبحث تعديل عرض "الكارت كارتين" بما يتوافق مع مصلحة عملائها
-
"Hitech4all.com"يفوز بجائزة ثقافة الجودة بالإعلام العربي من جامعة حمدان بن محمد الإلكترونية
اقرأ لهؤلاء
أصدقاؤك يفضلون:
كشف باحثون فى مستشفى بحوث الأطفال بنيويورك عن وجود طفرة جينية تمكن البكتيريا مقاومة العلاج بالمضادات الحيوية الفعالة.
كان الباحثون قد أجروا أبحاثهم على طفل رضيع يبلغ من العمر 6 أسابيع يعانى من سرطان الدم الحاد ويتم علاجه، في الوقت الذي وجد فيه عدوى فى مجرى الدم لبكتيريا / فانكومايسين/ المعوية المقاومة للمضادات الحيوية.
وقد أجرى الباحثون اختبارا لتسلسل الحمض النووى فى 22 عينة من مرضى سرطان الدم لفترة طويلة، حيث لوحظ حدوث طفرة جينية فى جين (ضزإ) ساهم بصورة مباشرة فى مكافحة العلاج بواسطة المضادات الحيوية على الرغم من إعطاء المرضى جرعات مرتفعة من المضادات الحيوية.





